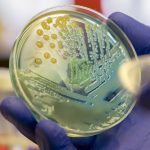

Космическият телескоп „Джеймс Уеб“ най-накрая пристигна в новия си дом. След изстрелването му по Коледа и месец на разгръщане и сглобяване в Космоса, новата космическа обсерватория достигна крайната си цел – място, известно като L2 и отдалечено от Земята на 1,5 млн. км.
„Насочването на телескопа към L2 е невероятно постижение на целия екип – каза мениджърът по пускането в експлоатация на „Джеймс Уеб“ Кийт Париш на пресконференция, обявяваща пристигането. – Последните 30 дни ги наричаме „30 дни на ръба“. Толкова сме горди, че преживяваме това. Но работата на екипа все още не е свършена. Най-доброто тепърва предстои“, допълва той.
Телескопът все още не може да започне научни изследвания. „Бебето още не е отворило очите си – каза Джейн Ригби от Центъра за космически полети на НАСА „Годард“ в Грийнбелт, Мери-
ленд. – Всичко, което правим, е да подготвим обсерваторията за извършване на трансформативна наука. Ето защо сме тук.“
Все още има задачи, които трябва да се свършат в следващите няколко месеца, преди телескопът да е готов да надникне в светлината на най-ранната Вселена или да почне да „шпионира“ извънземните атмосфери на екзопланетите, пише Science news.
„Това не означава, че има нещо нередно – казва астрономът Скот Фридман от Научния институт за космически телескопи в Балтимор, който управлява тази следваща фаза от пътуването на „Джеймс Уеб“. – Всичко може да върви перфектно и все пак ще отнеме шест месеца от стартирането, за да бъдат научните инструменти на телескопа готови за действие“, обобщава той.
Уважаеми читатели, в. „Аз-буки“ и научните списания на издателството може да закупите от НИОН "Аз-буки":
Address: София 1113, бул. “Цариградско шосе” № 125, бл. 5
Phone: 0700 18466
Е-mail: izdatelstvo.mon@azbuki.bg | azbuki@mon.bg